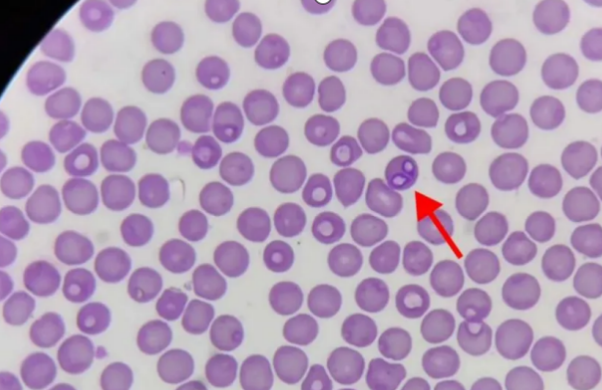
1765163711759019.png 2025SVr55aYq3B1756728542.png

(共用选项)(2025 预防 69-71)德国牧羊犬,3岁,体温升高,呈不规则稽留热,精神沉郁,可视粘膜苍白,尿液呈黄色,体表寄生硬蜱虫,采耳尖血染色如图。采取治疗的药物
硫酸喹啉脲、三氮脒及咪唑苯脲均有较好的疗效。
《兽药管理条例》第四十七条规定的按照假兽药处理的情形是()
猪,采食烂青菜后,站立不稳,呼吸困难,脉搏细弱,全身发绀,其可能的发病机制是(2016 真题上 89)
“槟榔肝”是指慢性肝淤血伴发肝细胞(2014 真题上 59)
一病死仔猪,剖检见颌下淋巴结和腹股沟淋巴结明显肿胀,呈灰白色,质地柔软,肺、肝和肾等表面均见有大小不一的灰白色隆起,切开病灶见灰黄色混浊的凝乳状物流出。确诊该病需进一步检査的项目是(2017 真题上 97)
与炎性渗出有关的因素是(2011 真题上 65)
磺胺类药抑制二氢叶酸合成酶的机制属于(2023 基础)
三羧酸循环中,发生底物水平磷酸化的反应为(2016 真题上 46)
目前,水产养殖中常发生的所谓“鱼类肝胆综合征”的肝脏切片中,可以看到肝脏肿大,被膜紧张,边缘钝圆,色变黄,切面隆起,有油腻感,质地脆软。该病在病因消除后通常可恢复正常,严重时易引发肝细胞
贫血对机体的影响取决于下列哪些因素
经营普药的企业必须具备的条件是()